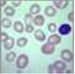
Megaloblastic Anemia

Practice Essentials
Folate (vitamin B9) is an essential water-soluble vitamin that occurs in fruits, green leafy vegetables, liver, and other foods. [1] Folic acid, the synthesized form of folate, is present in fortified foods (eg, breads, pasta) and supplements; however, the terms folate and folic acid are often used interchangeably. [2] Folate deficiency can result from inadequate diet, diseases that inhibit folate absorption, certain drugs, and congenital disorders; it may also be secondary to vitamin B12 deficiency. Alcoholism, pregnancy and lactation, hemolytic anemia, and dialysis can lead to folate deficiency. [1]
Presenting features of folate deficiency include the following:
-
Glossitis
-
GI signs and symptoms (anorexia, nausea, vomiting, abdominal pain, diarrhea)
-
Manifestations of anemia
-
Neuropsychiatric symptoms (eg, cognitive impairment, dementia, depression)
-
Patchy hyperpigmentation, especially particularly at the dorsal surfaces of the fingers, toes, and creases of palms and soles.
-
Low-grade fever
Folate deficiency in pregnancy can result in birth defects (anencephaly and spina bifida), which underlies the strong recommendation for folic acid supplementation in women of reproductive age. [2]
See Presentation for more detail.
A low serum folate level is suggestive of folate deficiency, but is not diagnostic. Testing to rule out cobalamin deficiency is very important because deficiency of folate and vitamin B12 produce overlapping neurologic manifestations, and both cause megaloblastic anemia. If there is strong clinical suspicion of folate deficiency but the serum folate level is normal and cobalamin deficiency has been ruled out, the red blood cell folate level may be measured. See Workup for more detail.
The dosage of folic acid needed to prevent or reverse folate deficiency varies with the clinical circumstances. Referral to a dietician may be indicated to ensure that the patient has appropriate dietary intake of folic acid. Fruits, vegetables, and fortified foods constitute the primary dietary source of folic acid. See Treatment and Medication for more detail.
Background
The prevalence of folate deficiency has decreased since many countries in the western hemisphere introduced a mandatory folic acid food fortification program starting in the late 1990s. People with excessive alcohol intake and malnutrition are still at high risk of folate deficiency. National Health and Nutrition Examination Survey (NHANES) data from 2003-2006 showed that certain groups, including women of childbearing age and non-Hispanic black women, are also at risk of folate deficiency, while some older adults are at risk of over-supplementation. [3]
Note the chart below.
Folic acid supplementation continues to be actively debated in the medical literature, with conflicting findings regarding its significance. While folate deficiency clearly predisposes to a number of health consequences, more recent studies raise concerns of toxicities and health consequences related to over-supplementation. Notable considerations regarding folate deficiency are as follows:
-
An association between folate deficiency and elevated homocysteine, a known marker for increased atherosclerosis risks [4]
-
Adjunctive therapy with folic acid in the form of L-methylfolate may improve outcomes in patients with depression, especially cases resistant to treatment with selective serotonin reuptake inhibitors (SSRIs). [10]
-
A long-recognized reduction in the incidence of neural tube defects with folic acid supplementation before and during pregnancy
-
Evidence of increased risk of preterm birth in pregnant women with folate deficiency [13]
-
Evidence that maternal folic acid supplementation before and during pregnancy may reduce the risk of childhood leukemia in the offspring. [14]
-
Evidence that folic acid supplementation may improve cognitive function, especially in people with hyperhomocysteinemia [15]
Folic acid supplementation clearly has significant public health implications.
Pathophysiology
Folic acid is composed of a pterin ring connected to p-aminobenzoic acid (PABA) and conjugated with one or more glutamate residues. It is distributed widely in green leafy vegetables, citrus fruits, and animal products. Humans do not generate folate endogenously because they cannot synthesize PABA, nor can they conjugate the first glutamate.
Folates are present in natural foods and tissues as polyglutamates because these forms serve to keep the folates within cells. In plasma and urine, they are found as monoglutamates because this is the only form that can be transported across membranes. Enzymes in the lumen of the small intestine convert the polyglutamate form to the monoglutamate form of the folate, which is absorbed in the proximal jejunum via both active and passive transport.
Within the plasma, folate is present mostly in the 5-methyltetrahydrofolate (5-methyl THFA) form, and is loosely associated with plasma albumin in circulation. The 5-methyl THFA enters the cell via a diverse range of folate transporters with differing affinities and mechanisms (ie, adenosine triphosphate [ATP]–dependent H+ cotransporter or anion exchanger). Once inside, 5-methyl THFA may be demethylated to THFA, the active form participating in folate-dependent enzymatic reactions. Cobalamin (B-12) is required in this conversion, and in its absence, folate is "trapped" as 5-methyl THFA.
From then on, folate no longer is able to participate in its metabolic pathways, and megaloblastic anemia results. Large doses of supplemental folate can bypass the folate trap, and megaloblastic anemia will not occur. However, the neurologic/psychiatric abnormalities associated with B-12 deficiency ensue progressively.
The biologically active form of folic acid is tetrahydrofolic acid (THFA), which is derived by the 2-step reduction of folate involving dihydrofolate reductase. THFA plays a key role in the transfer of 1-carbon units (such as methyl, methylene, and formyl groups) to the essential substrates involved in the synthesis of DNA, RNA, and proteins. More specifically, THFA is involved with the enzymatic reactions necessary to synthesis of purine, thymidine, and amino acid. Manifestations of folate deficiency thereafter, not surprisingly, would involve impairment of cell division, accumulation of possibly toxic metabolites such as homocysteine, and impairment of methylation reactions involved in the regulation of gene expression, thus increasing neoplastic risks.
A healthy individual has about 500-20,000 mcg of folate in body stores. Adults need to absorb approximately 400 mcg of folate per day in order to replenish the daily degradation and loss through urine and bile. Otherwise, signs and symptoms of deficiency can manifest after 4 months. The degree of folate absorption depends on its source. Approximately 50% of folate naturally occurring in food is bioavailable, whereas nearly 100% of folic acid supplements are absorbed when consumed fasting, and approximately 85% of folic acid supplementation is absorbed when consumed with food. [22]
Etiology
Folate deficiency can result from any of the following causes:
-
Inadequate ingestion
-
Impaired absorption
-
Impaired metabolism leading to inability to utilize absorbed folate
-
Increased requirement
-
Increased excretion
-
Increased destruction
Inadequate ingestion of folate-containing foods
Poor nutrition is prevalent among people with alcoholism and patients with psychiatric morbidities, as well as elderly people (due to conditions such as ill-fitting dentures, physical disabilities, and social isolation). Because folates are destroyed by prolonged exposure to heat, people of certain cultures that involve traditionally cooking food in kettles of boiling water may be predisposed to folate deficiency. Moreover, for patients with kidney or liver failure, anorexia and restriction of foods rich in protein, potassium, and phosphate contribute to decreased folate intake.
Impaired absorption
The limiting factor in folate absorption is its transport across the intestinal wall. Folate transport across the gut wall mainly is carrier mediated, saturable, substrate specific, pH dependent (optimal at low pH), sodium dependent, and susceptible to metabolic inhibitors. Passive, diffusional absorption also occurs, to a minor degree. With this in mind, a decreased absorptive area due to small bowel resection or mesenteric vascular insufficiency would decrease folate absorption.
Celiac disease and tropical sprue cause villous atrophy. The process of aging causes shorter and broader villi in 25% of the elderly population. Achlorhydria leads to elevation of gastric pH above the optimal level (ie, pH of 5) for folate absorption. Anticonvulsant drugs, such as phenytoin, interfere with mucosal conjugase, hence impairing folate absorption. Zinc deficiency also decreases folate absorption because zinc is required to activate mucosal conjugase. Bacterial overgrowth in blind loops, stricture formation, or jejunal diverticula likewise would decrease folate absorption. Hereditary folate malabsorption is a rare autosomal recessive disorder characterized by impaired intestinal folate absorption and impaired folate transport into the central nervous system. [23]
Impaired metabolism, leading to inability to utilize absorbed folate
Antimetabolites that are structurally analogous to the folate molecule can competitively antagonize folate utilization. Methotrexate and trimethoprim both are folate antagonists that inhibit dihydrofolate reductase. Hypothyroidism has been known to decrease hepatic levels of dihydrofolate reductase as well as methylene THFA reductase. Furthermore, congenital deficiency involving the enzymes of folate metabolism also can show impaired folate utilization. People with alcoholism can have very active alcohol dehydrogenase that binds folate and thus interferes with folate utilization.
Increased requirement
Factors that increase the metabolic rate and thus the folic requirement include the following:
-
Infancy (a period of rapid growth)
-
Pregnancy (rapid fetal growth)
-
Lactation (uptake of folate into breast milk)
-
Malignancy (increased cell turnover)
-
Concurrent infection (immunoproliferative response)
-
Chronic hemolytic anemia (increased hematopoiesis)
Increased excretion/loss
Increased excretion of folate can occur subsequent to vitamin B-12 deficiency. During the course of vitamin B-12 deficiency, methylene THFA is known to accumulate in the serum, which is known as the folate trap phenomenon. In turn, large amounts of folate filter through the glomerulus, and urine excretion occurs. Another mechanism of excess excretion occurs in people with chronic alcoholism who can have increased excretion of folate into the bile. Patients undergoing hemodialysis also have been known to have excess folate loss during procedures.
Increased destruction
Superoxide, an active metabolite of ethanol metabolism, is known to inactivate folate by splitting the folate molecule in half between the C9 and N10 position. The relationship between cigarette smoking and low folate levels has been noted as possibly due to folate inactivation in exposed tissue.
Epidemiology
Frequency
United States
The current standard of practice is that serum folate levels less than 3 ng/mL and a red blood cell (RBC) folate level less than 140 ng/mL puts an individual at high risk of folate deficiency. The RBC folate level generally indicates folate stored in the body, whereas the serum folate level tends to reflect acute changes in folate intake.
Data from the National Health and Nutrition Examination Survey (NHANES) 1999-2000 indicate the prevalence of low serum folate concentrations (< 6.8 nmol/L) decreased from 16% before folic acid fortification to 0.5% after folic acid fortification. [24] In elderly persons, the prevalence of high serum folate concentrations (>45.3 nmol/L) increased from 7% before fortification to 38% after fortification.
Subsequent to the initial NHANES studies, subjects in the 2003-2006 cohort were asked about their daily supplement use in order to better quantify their total daily intake of folic acid. [3] It was discovered that 34.5% of the participants took supplements containing folic acid. Certain groups were over-supplementing, while other groups were still receiving inadequate doses. The participants ages 51-70 years took the highest doses of folate (combined food and supplement), with 5% exceeding the tolerable upper intake level. Two groups were most likely to consume inadequate folate (below the recommended dietary allowance): women of childbearing age (17-19%) and non-Hispanic black women (23%). The study authors concluded that efforts need to be made both to monitor for over-supplementation in certain groups and to target increased supplementation in the groups at risk for deficiency.
Several studies have demonstrated that high-dose folate may increase the risk of cancer. [16, 17, 18, 19, 20, 21, 25] Specifically, increased risks of prostate and colorectal cancer have been noted. However, despite experimental evidence suggesting increased risk of breast cancer progression, [18] a comparison of 2,491 breast cancer cases individually matched to 2,521 controls in the European Prospective Investigation into Cancer and Nutrition (EPIC) found that plasma levels of folate were not significantly associated with the overall risk of breast cancer. [26]
It is particularly concerning that the groups who are over-supplementing are among the highest risk for accelerating the growth of malignancy through overuse of folic acid, while many in the groups that are under-supplementing are women who could confer benefits of folic acid supplementation to a developing fetus. Clearly, folic acid supplementation continues to be an important primary care and public health issue.
International
Nearly every country in the western hemisphere has mandatory folic acid flour fortification, and most European countries have policies recommending folic acid supplementation prior to conception and for the first 3 months of pregnancy. [27] Flour fortification with folic acid has been shown to result in significant improvements in folate status among women of reproductive age, in areas where folate deficiency is high. [28]
Casey et al examined the effects over 1 year of a free weekly iron-folic acid supplementation and deworming program in 52,000 Vietnamese women of childbearing age. [29] The investigators collected demographic data and blood and stool samples at baseline and at 3 and 12 months following the implementation of the program.
Findings included a mean Hb increase of 9.6 g/L (P < 0.001) and a reduction in the presence of anemia from 37.5% of the women at baseline to 19.3% at 12 months. [29] Iron deficiency was also reduced, from 22.8% at baseline to 9.3% by 12 months, as well as hookworm infection (76.2% at baseline to 23.0%) in the same period.
Mortality/Morbidity
Hematologic manifestations
Folate deficiency can cause anemia. The presentation typically consists of macrocytosis and hypersegmented polymorphonuclear leukocytes (PMNs). [30] More detailed laboratory findings are discussed in the Workup section.
The anemia usually progresses over several months, and the patient typically does not express symptoms as such until the hematocrit level reaches less than 20%. At that point, symptoms such as weakness, fatigue, difficulty concentrating, irritability, headache, palpitations, and shortness of breath can occur. Furthermore, heart failure can develop in light of high-output cardiac compensation for the decreased tissue oxygenation. Angina pectoris may occur in predisposed individuals due to increased cardiac work demand. Tachycardia, postural hypotension, and lactic acidosis are other common findings.
Less commonly, neutropenia and thrombocytopenia also will occur, although it usually will not be as severe as the anemia. In rare cases, the absolute neutrophil count can drop below 1000/mL and the platelet count below 50,000/mL.
Elevated serum homocysteine and atherosclerosis
Folate in the 5-methyl THFA form is a cosubstrate required by methionine synthase when it converts homocysteine to methionine. As a result, in the scenario of folate deficiency, homocysteine accumulates. Several recent clinical studies have indicated that mild-to-moderate hyperhomocystinemia is highly associated with atherosclerotic vascular disease such as coronary artery disease (CAD) and stroke. In this case, mild hyperhomocystinemia is defined as total plasma concentration of 15-25 mmol/L and moderate hyperhomocystinemia is defined as 26-50 mmol/L.
Genest et al found that a group of 170 men with premature coronary artery disease had a significantly higher average level of homocysteine (13.7 ± 6.4). [31] In another study, Coull et al found that among 99 patients with stroke or transient ischemic attacks (TIAs), about one third had elevated homocysteine. [32]
Elevated homocysteine levels might act as an atherogenic factor by converting a stable plaque into an unstable, potentially occlusive, lesion. Wang et al found that in patients with acute coronary syndromes, levels of homocysteine and monocyte chemoattractant protein-1 (MCP-1) were significantly higher. [33] MCP-1 is a chemokine characterized by the ability to induce migration and activation of monocytes and therefore may contribute to the pathogenesis of CAD. Homocysteine is believed to have atherogenic and prothrombotic properties via multiple mechanisms.
Bokhari et al found that among patients with CAD, the homocysteine level correlates independently with left ventricular systolic function. [34] The mechanism is unknown, but it may be due to a direct toxic effect of homocysteine on myocardial function separate from its effect on coronary atherosclerosis.
Although multiple observational studies have found a positive assocation between elevated plasma homocysteine levels and increased risk of atherosclerosis, randomized trials have not been able to demonstrate the utility of homocysteine-lowering therapy for outcomes other than stroke. [7, 8] In the Heart Outcomes Prevention Evaluation (HOPE) 2 trial, supplements combining folic acid and vitamins B-6 and B-12 did not reduce the risk of major cardiovascular events in patients with vascular disease. [35] Similarly, in the trial by Bonaa et al, treatment with B vitamins did not lower the risk of recurrent cardiovascular disease after acute myocardial infarction. [36]
While the risk of cardiac complications was not reduced with correction of hyperhomocysteinemia through supplementation, several studies have documented a reduction in stroke with supplementation. Two meta-analyses demonstrated a statistically significant reduction in stroke risk with folic acid supplementation at low doses (0.4-0.8 mg folic acid daily). [7, 8]
Pregnancy complications
Possible pregnancy complications secondary to maternal folate status may include spontaneous abortion, abruption placentae, congenital malformations (eg, neural tube defect), and severe language delay in the offspring. In a literature review, Ray et al examined 8 studies that demonstrated association between hyperhomocystinemia and placental abruption/infarction. [37] Folate deficiency also was a risk factor for placental abruption/infarction, although less statistically significant. [38]
Several observational and controlled trials have shown that neural tube defects can be reduced by 80% or more when folic acid supplementation is started before conception. In countries like the United States and Canada, the policy of widespread fortification of flour with folic acid has proved effective in reducing the number of neural tube defects. [39]
Although the exact mechanism is not understood, a relative folate shortage may exacerbate an underlying genetic predisposition to neural tube defects.
In a prospective observational study in Norway, where food is not fortified with folic acid, lack of supplementation with folic acid from 4 weeks before to 8 weeks after conception was associated with increased risk of severe language delay in the child at age 3 years. [40] No association between folic acid supplementation and gross motor skills was reported.
A more recent Norwegian prospective cohort study reexamined the maternal use of supplemental folic acid prior to and during pregnancy and demonstrated an association between child autism and lack of supplementation. There was no association between maternal folic acid supplementation and child Asperger syndrome or pervasive developmental disorder-not otherwise specified. [11]
Effects on carcinogens
Diminished folate status has historically been associated with enhanced carcinogenesis. [22] As recently as 2002, authors cited epidemiologic and laboratory data demonstrating that folic acid intake was inversely related to colon cancer risk. [41] The proposed mechanisms by which folic acid deficiency led to increased carcinogenesis included chromosomal breaks due to massive incorporation of uracil into human DNA. [42] and DNA strand breaks and hypomethylation within the P53 gene. [43]
More recently, a number of studies have demonstrated that folic acid supplementation can actually increase the risk of cancer.
A randomized controlled clinical trial from 1994-2004 examining the use of folic acid for the prevention of colorectal adenomas not only demonstrated that folic acid supplementation did not reduce colorectal adenoma risk, but suggested that this supplementation may increase the risk of colorectal neoplasia. This study demonstrated that folic acid supplementation increased the risk of having 3 or more adenomas. [21]
Prior to this study, authors had observed an increase in the rate of colorectal carcinomas in the United States and Canada in the 1990s, which was related temporally to the implementation of the mandatory folic acid supplementation government policies. They hypothesized that the addition of folic acid supplementation to American and Canadian diets was at least in part responsible for the rise in colorectal cancers. [20]
Similar conclusions were drawn by authors who studied a rise in colorectal cancers rates after a folic acid fortification program in Chile. [19] Folic acid supplementation has also been implicated in the development of prostate cancer, [17] and biochemical researchers have demonstrated that increasing folic acid levels led to dose-dependent down-regulation of tumor suppressor genes in breast cancer. [18]
In patients with inflammatory bowel disease, however, folic acid supplementation may reduce colorectal cancer risk. A systematic review and meta-analysis of 10 studies reporting on 4517 patients found an overall protective effect for folic acid supplementation on the development of colorectal cancer in this population, with a pooled hazard ratio of 0.58 (95% confidence interval, 0.37-0.80). [44]
The debate over the safety of widespread folic acid supplementation will certainly continue in the medical literature in the years to come. Care should be taken to ensure that individuals do not consume a greater-than-recommended dietary allowance of folic acid, and special consideration should be given to patients with history of colorectal adenomas and those at high risk for cancer.
Effects on cognitive function
Several studies have shown that an elevated homocysteine level correlates with cognitive decline. In Herbert's classic study in which a human subject (himself) was in induced folate deficiency from diet restriction, he noted that CNS effects, including irritability, forgetfulness, and progressive sleeplessness, appeared within 4-5 months. Interestingly, all CNS symptoms were reported to disappear within 48 hours after oral folate intake. [45]
Low folate and high homocysteine levels are a risk factor for cognitive decline in high-functioning older adults [46] and high homocysteine level is an independent predictor of cognitive impairment among long-term stay geriatric patients. [47]
Mechanistically speaking, current theory proposes that folate is essential for synthesis of S- adenosylmethionine, which is involved in numerous methylation reactions. This methylation process is central to the biochemical basis of proper neuropsychiatric functioning.
Despite the association of high homocysteine level and poor cognitive function, homocysteine-lowering therapy using supplementation with vitamins B-12 and B-6 was not associated with improved cognitive performance after two years in a double-blind, randomized trial in healthy older adults with elevated homocysteine levels. [48]
Sex- and Age-related Demographics
Pregnant women are at higher risk of developing folate deficiency because of increased requirements.
Certain elderly people also may be more susceptible to folate deficiency, as a result of their predisposition to mental status changes, social isolation, low intake of leafy vegetables and fruits, malnutrition, and comorbid medical conditions. The greatest risk appears to be among low-income populations and institutionalized elderly people; risk is lower in the free-living elderly population. In fact, analysis of 2003-2006 NHANES cohort showed that adults older than 50 years are the most likely to receive folic acid over-supplementation due to the consumption of both fortified foods and supplements containing folic acid. [3]
A study of 2922 children in a population-based cohort study revealed an association beween early high folic acid intakes and lower body weight and body mass index (BMI). This requires further investigation. [49]
Patient Education
Educate patients regarding proper nutrition, including eating fruits and vegetables. Educate patients regarding the need to reduce alcohol ingestion. Discuss the need to take folic acid supplementation. For patient education information, see the Folic Acid Directory.
No randomized clinical trial has proven that lowering the homocysteine concentration can improve cognition or lower the incidence of cardiovascular disease (CVD). Until new evidence is available, clinicians should not promise patients that folate supplementation will improve cognition or decrease cardiovascular risk.
-
The chemical structure of folic acid and amethopterin (methotrexate), a folic acid antagonist, shows the similarity of structure.
-
The transformation of formiminoglutamic acid to glutamic acid is dependent upon both vitamin B-12 and tetrahydrofolate. In contrast, the transformation of homocysteine to methionine is a vitamin B-12–dependent reaction.
-
Both folic acid and vitamin B-12 participate in the synthesis of DNA and RNA.
-
Histologically, the megaloblastosis caused by folic acid deficiency cannot be differentiated from that observed with vitamin B-12 deficiency.
-
Peripheral smear of blood in a patient with pernicious anemia. Macrocytes are observed and some of the red blood cells show ovalocytosis. A 6-lobed polymorphonuclear leucocyte is present.
-
Bone marrow aspirate from a patient with untreated pernicious anemia. Megaloblastic maturation of erythroid precursors is shown. Two megaloblasts occupy the center of the slide with a megaloblastic normoblast above.